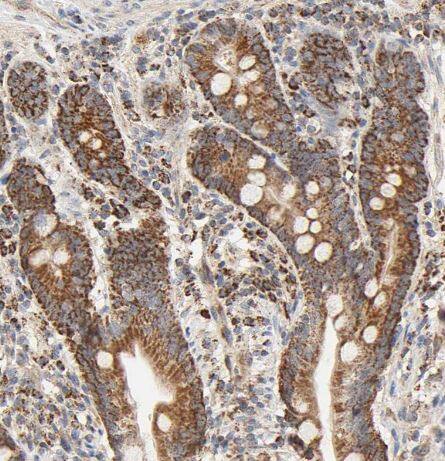
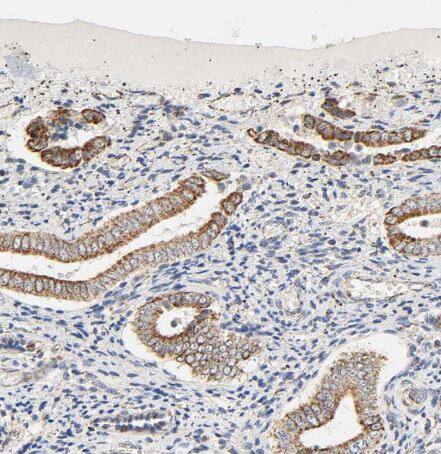

ZMAT5 Antibody - BSA Free
Novus Biologicals, part of Bio-Techne | Catalog # NBP1-85794

Key Product Details
Species Reactivity
Validated:
Human
Predicted:
Mouse (94%), Rat (93%). Backed by our 100% Guarantee.
Applications
Immunohistochemistry, Immunohistochemistry-Paraffin, Western Blot, Immunocytochemistry/ Immunofluorescence
Label
Unconjugated
Antibody Source
Polyclonal Rabbit IgG
Format
BSA Free
Concentration
Concentrations vary lot to lot. See vial label for concentration. If unlisted please contact technical services.
Product Specifications
Immunogen
This antibody was developed against Recombinant Protein corresponding to amino acids: RKKHLNGLQHLKAKKVWYDMFRDAAAILLDEQNKRPCRKFLLTGQCDFGSNCRFSHMSERDLQELSIQVEEERRAREWLLDAPELPEGHLEDWLEKRAKRLSSAPS
Clonality
Polyclonal
Host
Rabbit
Isotype
IgG
Scientific Data Images for ZMAT5 Antibody - BSA Free
Staining of human cerebral cortex shows strong cytoplasmic positivity in neurons.
Staining of human cerebral cortex shows strong cytoplasmic positivity in neurons.Staining of human tonsil shows strong cytoplasmic granular positivity in germinal center cells.
Staining of human tonsil shows strong cytoplasmic granular positivity in germinal center cells.Staining of human duodenum shows strong cytoplasmic granular positivity in glandular cells.
Staining of human duodenum shows strong cytoplasmic granular positivity in glandular cells.Applications for ZMAT5 Antibody - BSA Free
Application
Recommended Usage
Immunocytochemistry/ Immunofluorescence
0.25-2 ug/ml
Immunohistochemistry
1:50 - 1:200
Immunohistochemistry-Paraffin
1:50 - 1:200
Western Blot
0.04-0.4 ug/ml
Application Notes
For IHC-Paraffin, HIER pH 6 retrieval is recommended. ICC/IF Fixation Permeabilization: Use PFA/Triton X-100.
Formulation, Preparation, and Storage
Purification
Affinity purified
Formulation
PBS (pH 7.2) and 40% Glycerol
Format
BSA Free
Preservative
0.02% Sodium Azide
Concentration
Concentrations vary lot to lot. See vial label for concentration. If unlisted please contact technical services.
Shipping
The product is shipped with polar packs. Upon receipt, store it immediately at the temperature recommended below.
Stability & Storage
Store at 4C short term. Aliquot and store at -20C long term. Avoid freeze-thaw cycles.
Background: ZMAT5
Alternate Names
U11/U12 small nuclear ribonucleoprotein 20 kDa protein, U11/U12 snRNP 20 kDa protein, U11/U12 snRNP 20K, U11/U12-20K, zinc finger matrin-type protein 5, zinc finger, matrin type 5, zinc finger, matrin-type 5
Gene Symbol
ZMAT5
Additional ZMAT5 Products
Product Documents for ZMAT5 Antibody - BSA Free
Product Specific Notices for ZMAT5 Antibody - BSA Free
This product is for research use only and is not approved for use in humans or in clinical diagnosis. Primary Antibodies are guaranteed for 1 year from date of receipt.
Loading...
Loading...
Loading...
Loading...

![Western Blot: ZMAT5 Antibody - BSA Free [NBP1-85794] ZMAT5 Antibody - BSA Free Western Blot: ZMAT5 Antibody - BSA Free [NBP1-85794]](https://resources.bio-techne.com/images/products/nbp1-85794_rabbit-polyclonal-zmat5-antibody-24420259342977.jpg)
![Immunocytochemistry/ Immunofluorescence: ZMAT5 Antibody [NBP1-85794] ZMAT5 Antibody - BSA Free Immunocytochemistry/ Immunofluorescence: ZMAT5 Antibody [NBP1-85794]](https://resources.bio-techne.com/images/products/nbp1-85794_-immunocytochemistry-immunofluorescence-639174076592721324.jpg)